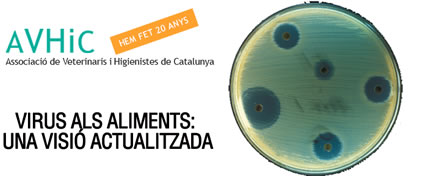
virus alimentos

La Associació de Veterinaris i Higienistes de Catalunta (AVIHC) organiza esta conferencia que tratará sobre los virus como contaminantes de los alimentos: cuales son y cómo se pueden controlar. La contaminación alimentaria por virus está relacionada con un alto porcentaje de casos de gastroenteritis intestinal. El evento se celebrará en Barcelona el próximo 12 de noviembre.
Virus en los alimentos: una visión actualizada
El 18% de gastroenteritis intestinales están relacionados con los norovirus. Los virus entéricos, o digestivos, son muy estables y resistentes: no son sensibles ni al frio, ni a la cocción, ni al pH ácido o a procesos como la pasteurización o la liofiliación.
Muchos alimentos pueden tener este tipo de contaminación: las plantas aromáticas, las especies, vegetales crudos, la fruta (fresca, congelada o seca), los crustáceos y molúscos, asi como las aguas.
También las superficies en contacto con los alimentos pueden verse afectadas por la contaminación vírica.
Silvia Bofill, Doctora en Biología y profesora del Departament de Microbiologia de la Facultat de Biologia de la Universitat de Barcelona, será la ponente en esta conferencia, organizada por AVIHC en colaboración con el Col·legi Oficial de Veterinaris de Barcelona.
Lugar: Col·legi oficial de Veterinaris de Barcelona, Av. República Argentina, 21-25, Barcelona
Fecha: jueves 12 de noviembre de 2015
Horario: 19:00h
Inscripciones:
La asistencia es gratuita, con inscripción previa en la web www.avhic.com.